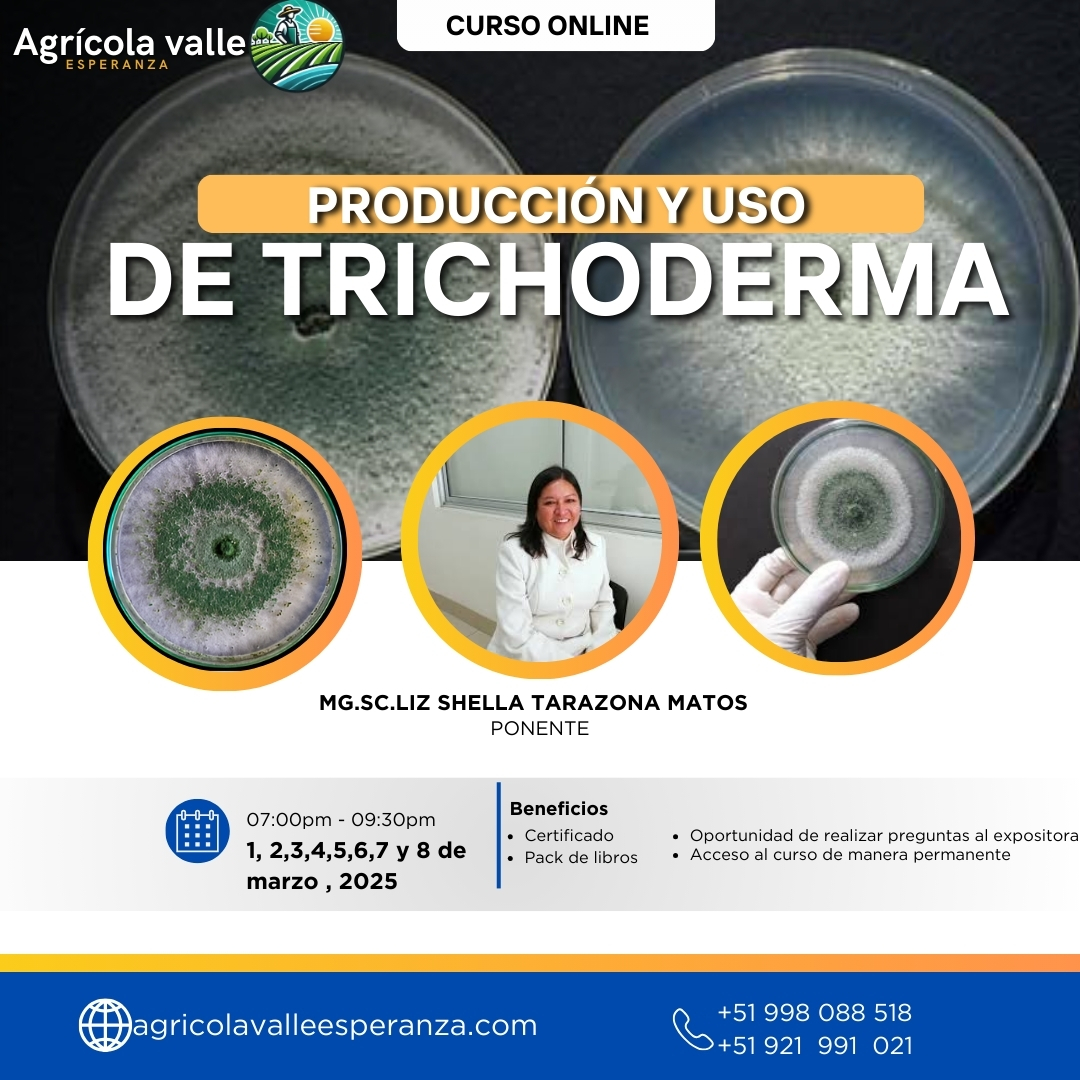
Enfermedades

Capacitación
Agricultura
Certificación
Referencia en capacitación para la agricultura
Soluciones integrales para el agro moderno: capacitación, tecnología y herramientas para el desarrollo agrícola sostenible.
0+
Personas capacitadas
60+
Cursos impartidos
500+
Horas de formación

Aprendizaje aplicado
Contenido práctico para decisiones reales en campo.
Nuestros cursos y recursos
Acceda a formación, tecnología y materiales para fortalecer sus competencias técnicas.
📜
Cursos
Cursos certificados
Programas con constancia y validación en línea.
Ver cursos
👨🏫
Experiencia
Ponente experto
Acompañamiento basado en práctica agrícola real.
Conocer más
📓
Flexible
Aprendizaje flexible
Acceda al contenido cuando lo necesite.
Inscribirse
✂️
Tienda
Herramientas agrícolas
Equipos para mejorar productividad y control.
Ver herramientas
🍃
Tecnología
Medidor de clorofila
Medición precisa para manejo del cultivo.
Ver producto
🔬
Laboratorio
Microscopio biológico
Análisis para diagnóstico y monitoreo.
Ver producto
📚
Recursos
Biblioteca virtual
Material técnico para consulta y estudio.
Explorar
👥
Comunidad
Comunidad agrícola
0+ profesionales capacitados.
Conectar
CURSOS DE CAPACITACIÓN
Programas diseñados para potenciar tus conocimientos en agricultura moderna, biotecnología y manejo de suelos.
Todos
Abonos Orgánicos
Control Biológico
Micorrizas
Análisis de Suelos